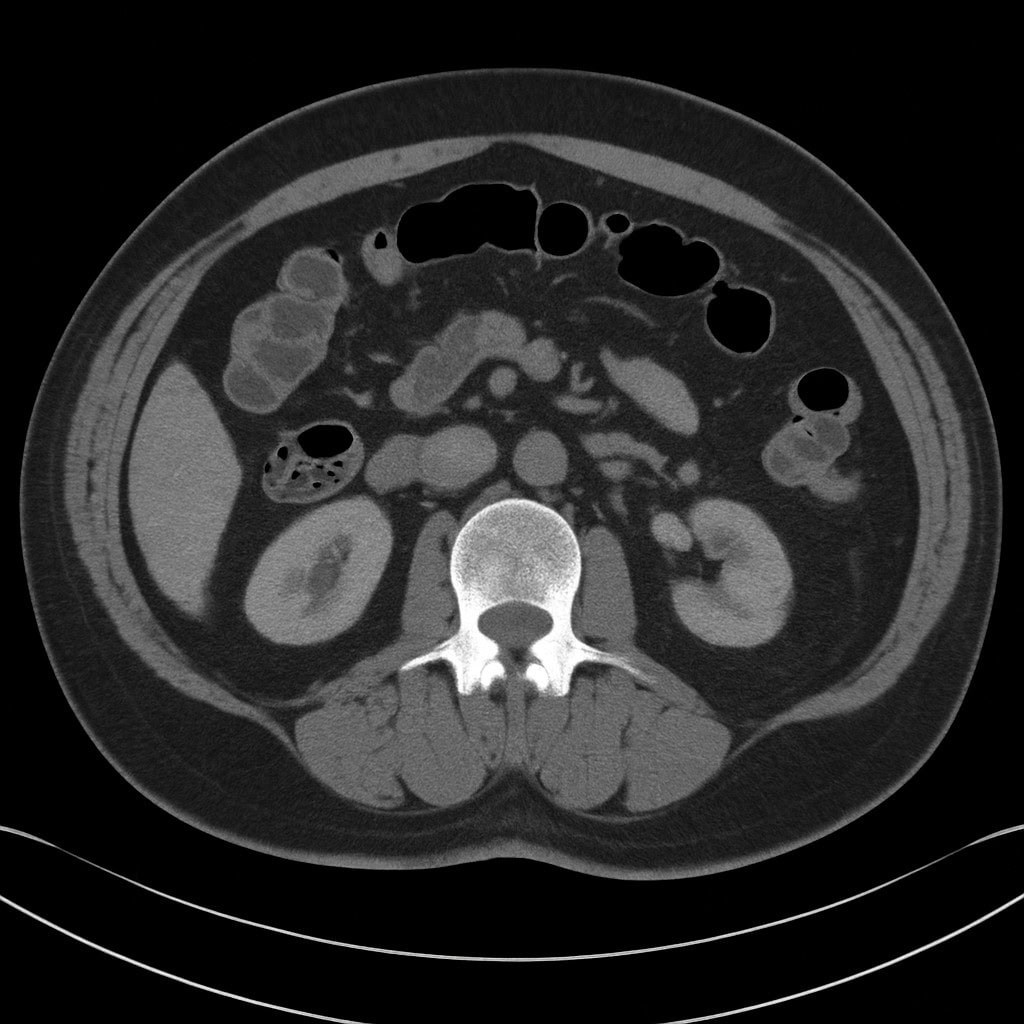
大腸憩室炎 CT検査 診断方法の解説

2025年12月27日
大腸憩室炎(だいちょうけいしつえん)は、大腸の壁にできた小さな袋(憩室)に細菌が入り込み、炎症を起こす病気です。
突然の腹痛や発熱を引き起こすことがあり、軽症なら飲み薬で改善しますが、重症化すると入院や手術が必要になる場合もあります。
40歳頃から急に増える “とても身近な病気” で、下腹部痛・発熱・お腹の張り・便通の変化があるときに真っ先に疑われる疾患の一つです。
この記事では 症状・原因・検査(CT/大腸内視鏡)・治療・再発予防 を、医師の視点からわかりやすくまとめています。
はじめての方でも理解しやすいよう、専門用語も丁寧に解説します。

大腸憩室炎とは
大腸憩室炎(だいちょうけいしつえん)は、大腸の壁にできた小さな袋(憩室)に便や細菌が入り込み、炎症が起きてしまう病気です。突然の腹痛や発熱を伴うことが多く、軽症なら飲み薬で治りますが、悪化すると入院や手術が必要になる場合もあります。まずは、憩室炎がどのように起こるのかを理解することが大切です。

大腸憩室炎が起こるしくみ
大腸憩室炎は、大腸の壁の弱い部分が腸の圧力で押し出されてできた小さな袋(憩室)に、便のかけらや細菌が入り込み、周囲の組織が炎症を起こした状態 です。
憩室は加齢や便秘などによって形成されやすく、そこに便が詰まると細菌が繁殖し、赤く腫れたり強い痛みを引き起こします。炎症が進むと膿がたまったり(膿瘍)、まれに腸管に穴が開く(穿孔)などの重症例に進展することもあります。
イメージとしては、「壁の弱い部分にできた小さなポケットに汚れが溜まり、その部分が炎症を起こして腫れてしまう」状態 です。
大腸憩室(憩室症)との違い
| 項目 | 大腸憩室(憩室症) | 大腸憩室炎 |
|---|---|---|
| 状態 | 袋(憩室)があるだけの状態 | 袋に炎症が起きている状態 |
| 症状 | ほとんど無症状 | 腹痛・発熱・便通異常・下血など |
| 治療 | 生活習慣改善が中心 | 抗菌薬・絶食・入院・手術の可能性 |
大腸憩室炎は 「憩室がある」人に起きる合併症 です。
大腸憩室そのものについて詳しく知りたい方は、こちらもご覧ください。
👉 大腸憩室症とは?数字で知る「高齢化で増える大腸の病気(大腸憩室炎・大腸憩室出血)」
大腸憩室炎で特に知っておきたいポイント
- ✔ 急な下腹部痛や発熱の原因になりやすい
- ✔ 憩室症(袋があるだけ)とは全く違う病態である
- ✔ 入院が必要なケースもあり、油断できない
- ✔ CT検査で正確に診断する
- ✔ 大腸内視鏡は鑑別や出血時の治療に用いる
- ✔ 食事・生活習慣が再発予防に重要
- ✔ 再発しやすいため、正しい理解が大切
大腸憩室炎の症状
大腸憩室炎の主な症状は「左下腹部の痛み」と「発熱」です。これに加えて、下痢や便秘などの便通の変化、全身倦怠感などが出ることもあります。痛みが急に強くなったり、歩くとお腹に響くような痛みがある時は、すぐに受診が必要です。なお、若い方の場合は、左下ではなく右下のお腹が痛むこともあります
典型的な症状
大腸憩室炎で最も多いのが 左下腹部の痛み です。
これは、S状結腸が大腸の中でもカーブが強く、内圧が高くなりやすい構造 になっているためです。
その結果、この部位に憩室ができやすく、炎症(憩室炎)もここで起こりやすくなります。
このため、典型的には次のような症状がみられます。腹部の自発痛・腹部の圧痛・歩行による腹痛の増悪などが特徴です。
大腸憩室炎でよくみられる症状(典型例)
- ✔ 左下腹部の鋭い痛み・鈍痛(S状結腸に憩室が多いため)
- ✔ 38℃前後の発熱
- ✔ お腹の張り(腹部膨満)
- ✔ 吐き気・食欲低下
- ✔ 歩くと響く、押すと強く痛む(炎症部位が動きで刺激されるため)

特に「押されると強く痛む/動くと響く痛み」は憩室炎に典型的で、
盲腸炎(虫垂炎)との鑑別 が必要になることもあります。
便通異常(下痢・便秘)がおこる理由
大腸憩室炎では、腸の炎症により蠕動運動(ぜんどう運動)が乱れ、
下痢と便秘の両方 が起こり得ます。
大腸憩室炎でみられる便通異常
- ✔ 便が細くなる
- ✔ 便秘が続く(排便後に痛みが強くなることも)
- ✔ 頻回の下痢・軟便
- ✔ 便秘と下痢を繰り返す
炎症により腸管がむくみ、腸管内腔が狭くなるため、
便が通りにくくなり、便秘〜下痢が生じます。
右側憩室炎の症状(若年層に多い)
日本人は右側結腸(盲腸・上行結腸)に憩室ができやすいため、
若い人では 右下腹部痛 を呈する右側憩室炎が多くみられます。
右側憩室炎は 虫垂炎と症状が似ている ため、CTでの鑑別が重要です。

右側憩室炎でみられる主な症状
- ✔ 右下腹部の痛み(虫垂炎と間違われやすい)
- ✔ 微熱〜38℃の発熱
- ✔ 押すと痛む圧痛が強い
- ✔ 吐き気や食欲低下
危険な症状(受診を急ぐべきサイン)
憩室炎が悪化すると、膿瘍、穿孔、敗血症など
緊急治療が必要な状態に進行することがあります。
以下の症状がある場合は、早めの医療機関受診が必要です。
大腸憩室炎で注意すべき「危険な症状」
- ✔ 強い腹痛が急激に悪化する(穿孔の可能性)
- ✔ 38.5℃以上の高熱が続く(膿瘍形成の可能性)
- ✔ 血便・下血がある(憩室出血の可能性)
- ✔ 立てないほどの激痛(緊急処置が必要)
- ✔ 吐き気や嘔吐が強い(水分摂取が難しい・腸閉塞の疑い)
大腸憩室炎の原因とリスク因子
大腸憩室炎は、大腸にできた袋状のくぼみ(憩室)に炎症が起きる病気です。ただし、その発症には大腸の構造、腸管内の圧力、年齢、生活習慣など、さまざまな要因が複雑に絡み合っています。
大腸憩室ができる主な原因
憩室は、大腸壁の弱い部分が腸内圧によって外側へ押し出されるようにして形成されます。
特に S状結腸は曲がりが強く内圧がかかりやすいため、憩室ができやすい部位です。

憩室(憩室症)ができる主な原因
- ✔ 加齢(大腸壁が弱くなる)
- ✔ S状結腸の構造(屈曲が強く内圧が高くなりやすい)
- ✔ 便秘やいきみ(腹圧・腸内圧の上昇)
- ✔ 低食物繊維食(便が硬くなりやすい)
憩室炎が起こるメカニズム
大腸憩室炎は、憩室の内部に入り込んだ便のかけら(便塊)がとどまり、
その周囲で細菌が増えることで始まります。
憩室は筋層が欠けた構造(仮性憩室)で壁が弱く、
細菌が増えると炎症が壁内に広がり、周囲の脂肪織にも波及しやすいことが特徴です。
憩室が複数あっても、炎症が起こる仕組みは同じです。
憩室炎の進行メカニズム
大腸憩室炎を起こしやすくするリスク因子
炎症そのものの仕組みは共通ですが、
憩室炎を起こしやすくする体質・生活習慣 は存在します。
憩室炎の主なリスク因子
- ✔ 加齢(憩室保有率の増加)
- ✔ 肥満(特に内臓脂肪の増加)
- ✔ 喫煙
- ✔ 低食物繊維食・不規則な生活
- ✔ NSAIDs・アスピリンの長期内服(出血・炎症リスク)
大腸憩室炎の診断方法
大腸憩室炎の診断では、症状だけで判断するのは難しく、
“どこが炎症を起こしているのか/どれくらい広がっているのか” を
正確に把握する必要があります。
特に CT検査 は診断の中心であり、重症度の評価にも欠かせません。
| 検査 | 目的 | わかること |
|---|---|---|
| 腹部CT検査 |
・憩室炎の診断に最も有用 ・炎症の範囲・重症度評価 |
・腸壁の肥厚 ・脂肪織濃度上昇 ・膿瘍・穿孔の有無 ・他疾患との鑑別 |
| 血液検査 |
・炎症の有無と程度を確認 ・重症度の把握 |
・白血球増加 ・CRP上昇 ・重症化の兆候 |
| 大腸内視鏡検査 |
・急性期は避ける ・炎症改善後に鑑別目的で実施 |
・大腸がん・IBD・ポリープの鑑別 ・出血時の止血治療が可能 |
🩺 なぜCT検査が“第一選択”なのか?
CT検査が大腸憩室炎の診断で重視される理由は次の通りです。
- 憩室炎に特徴的な所見(腸管壁肥厚・周囲脂肪織濃度上昇など)が明瞭に描出できる
- 膿瘍・穿孔・瘻孔などの合併症の有無と広がりを評価できる
- 虫垂炎や虚血性腸炎、大腸がん、炎症性腸疾患など、他の腹痛の原因疾患との鑑別に有用
- 人体への侵襲が比較的少ない検査でありながら、一度の撮影で多くの情報を得ることができる
腹痛を訴える患者さんでは、大腸憩室炎だけでなくさまざまな疾患の可能性があるため、
CTで炎症の部位と程度、合併症の有無を評価することが、
外来で経過観察とするか入院治療とするか、どのような抗菌薬治療を選択するかといった
治療方針の決定に直結します。
🔎 急性期に大腸内視鏡を避ける理由
急性期に内視鏡を避ける理由
・空気で腸を膨らませるため、穿孔(穴があく)リスクがある・炎症で腸壁が脆くなっている
・痛み・発熱で患者が耐えられない
炎症が落ち着いた数週間後に大腸内視鏡検査を行い、
大腸がんや炎症性腸疾患(潰瘍性大腸炎・クローン病)、感染性腸炎、虚血性腸炎などの
他疾患を除外します。
大腸憩室炎の治療
大腸憩室炎の治療は、炎症の広がり方と合併症の有無 によって大きく異なります。
特に Hinchey(ヒンチー)分類 は、憩室炎の重症度を客観的に評価する国際的な基準で、
治療方針(外来治療・入院治療・外科治療)を決定する際に非常に重要です。
Hinchey分類とは?
憩室炎による炎症・膿瘍・穿孔・腹膜炎の程度を分類したもの。
I → II → III → IV に進むほど重症。
参考文献:Danny O. Jacobs. Diverticulitis. N Engl J Med 2007;357:2057-2066

| 分類 | 病態 | 治療方針 |
|---|---|---|
| Stage 1 |
局所憩室炎、傍結腸 or 間膜内に小膿瘍形成 ・膿瘍が5cm未満:保存的治療 ・膿瘍が5cm以上:ドレナージ(可能なら経皮的) |
・抗菌薬(内服 / 点滴) ・食事制限(低残渣 or 一時的絶食) ・外来 or 短期入院 ・疼痛管理・水分補正 |
| Stage 2 | 後腹膜 or 骨盤内に膿瘍形成(遠隔膿瘍) |
・入院での抗菌薬点滴 ・膿瘍に対するドレナージ(経皮・経直腸・開腹など) ・栄養管理(絶食 → 低残渣) ・バイタル・炎症反応のモニタリング |
| Stage 3 | 化膿性腹膜炎(膿性腹水を伴う汎発性腹膜炎) |
・緊急手術の適応 ・腹腔内洗浄+炎症部位の処置 ・術後の抗菌薬・輸液・集中治療管理 |
| Stage 4 | 糞便性腹膜炎(便が腹腔内に漏出) |
・緊急手術の適応(腸切除 ± 人工肛門) ・術後は集中治療管理(ICUレベル) |
大腸憩室炎の再発予防
大腸憩室炎は治療が終わったあとも再発しやすく、
約20〜40%が再発する と報告されています。
生活習慣を整えることで再発リスクを下げられるため、
「何を気をつければいいか」を正しく知ることが大切です。
再発予防のポイント
- 食物繊維を十分に摂る
- 便秘を防ぎ、腸の内圧を上げない
- NSAIDsの常用を避ける
- 肥満・内臓脂肪を減らす
- 喫煙・過度な飲酒に注意
食物繊維をしっかり摂る

食物繊維が不足すると便が硬くなり、大腸に強い圧力がかかります。これは憩室に負担をかけ、再発しやすくなるため、毎日の食事で少しずつ摂取量を増やすことが大切です。
- 成人男性:21g以上/日
- 成人女性:18g以上/日
⚠ 日本人の平均摂取量は約14gで、明らかに不足しています。
- 朝食にオートミールを加える
- サラダだけでなく、海藻・豆類・きのこを取り入れる
- 白米を雑穀米にする
複数のコホート研究では、「高食物繊維食が憩室炎の再発率を下げる可能性」が示されています。
特に可溶性食物繊維は、腸内細菌叢に作用して炎症を抑える経路が指摘されています。
急性期には繊維の摂取を控えるため、炎症が完全に治まったあとに徐々に増やすのが推奨されます。
便秘を予防する
- 毎日1.5〜2Lを目安に水分をとる
- 朝食をしっかり食べて腸の動きを促す
- 便意を我慢しない
- ウォーキングなど軽い運動を習慣化
便秘により腸内圧が上昇すると、憩室の入口(neck)に便が入り込みやすくなり、便塊が停滞して炎症が誘発されます。
腸管蠕動を整えるためには、以下の4つが重要です:
大腸憩室炎を再発させやすい生活習慣とその理由
以下の4つは、研究でも再発リスクを高める可能性が報告されており、特に注意が必要です。
NSAIDsは腸粘膜を刺激し、潰瘍形成・血流低下を起こすため、憩室炎・憩室出血のリスクが上がると報告されています。
痛み止めが必要な場合は、✓ アセトアミノフェン(カロナール)がより安全とされています。
内臓脂肪が多いと、炎症性サイトカイン(TNF-αなど)が増え、腸壁のバリア機能が低下します。
そのため憩室炎の再発率が高くなる傾向があり、体重管理は重要です。
喫煙は腸管の血流を悪化させ、炎症の治癒を遅らせます。
憩室炎再発との関連を示す研究もあり、禁煙が望ましいと考えられています。
大量の飲酒は腸粘膜を刺激し、炎症を助長します。
加えて、脂質中心・肉中心の食事は腸内細菌叢を変化させ、憩室炎のリスクを増やす可能性があります。
適度な飲酒・バランスのとれた食事を心がけましょう。
再発予防のまとめ
- 食物繊維を十分に摂る
- 便秘を防ぎ、腸の内圧を上げない
- NSAIDsの常用を避ける
- 肥満・内臓脂肪を減らす
- 喫煙・過度な飲酒に注意
大腸憩室炎で「受診が必要なサイン」とは?
大腸憩室炎は、軽い腹痛だけでおさまることもあれば、短時間で悪化して膿瘍・穿孔・腹膜炎へ進行することがあります。
「ただの胃腸炎だろう」と自己判断するのは危険です。
ここでは、どんな症状が出たら受診すべきかをわかりやすく整理します。

まずは「早めの受診」を検討すべき症状
次のような症状は、軽症の憩室炎の初期段階の可能性があり、早めの受診が安心です。
- 数日続く下腹部の痛み(特に片側でじわじわ痛む)
- 37.5〜38℃前後の発熱が続く
- お腹の張りや違和感が強まってきている
- 食欲が落ちている、全身のだるさが続く
- 市販薬(整腸剤・解熱剤)を飲んでも改善しない
特に過去に憩室炎を経験したことのある方は、「前と似た痛み」が出た段階で受診することが大切です。
迷わず救急受診を検討すべき危険なサイン
以下の症状は重症憩室炎(膿瘍・穿孔・腹膜炎・大量出血)の可能性があり、救急受診を検討してください。
- 突然の強い腹痛で動けない・歩けないほど痛い
- お腹全体が硬く感じる(腹膜刺激症状)
- 38.5℃以上の高熱や悪寒が続く
- 冷や汗・強いふらつき・顔面蒼白がある
- 便器が真っ赤になるほどの大量の血便
- 激しい吐き気・嘔吐で水分がとれない
- 脈が速い、血圧が低い、意識がもうろうとしている
様子を見ても良い場合・すぐ相談すべき場合の違い
症状だけでは憩室炎の軽重を判断できません。
CT検査で初めて重症度がわかることも多いため、以下を目安にしてください。
| 様子を見てよいケースの目安 | すぐ医療機関に相談すべきケース |
|---|---|
|
|
大腸憩室炎は「少しおかしいな」と思った段階で早めに受診することが、重症化を防ぐいちばんの近道です。

大腸憩室炎に関するよくある質問(FAQ)
大腸憩室炎は自然に治ることがありますか?放置しても問題ありませんか? ▼
大腸憩室炎は再発しやすい病気ですか?再発率はどの程度ですか? ▼
大腸憩室炎の際に適した食事はありますか?避けた方がよい食品はありますか? ▼
大腸憩室炎の治療後、大腸内視鏡検査はいつ受けるべきですか? ▼
大腸憩室炎の時に痛み止め(ロキソニンなど)を飲んではいけないと聞きました。本当ですか? ▼
大腸憩室炎で入院や手術が必要になるのはどのような場合ですか? ▼
便に血が混じっていました。憩室炎や憩室出血の可能性はありますか? ▼
右下のお腹が痛くて熱もあります。憩室炎でしょうか?それとも盲腸(虫垂炎)でしょうか? ▼
大腸憩室炎まとめ
この記事の要点
- 大腸憩室炎は、憩室(小さな袋)に便が入り込み細菌が増えることで起こる炎症
- 典型的な症状は左下腹部痛・発熱・お腹の張り
- 右側の憩室炎は虫垂炎と区別が難しい
- 診断の中心はCT検査(重症度分類も可能)
- 治療は Hinchey分類に基づき、軽症は外来・重症は入院や手術が必要
- 再発予防には便秘予防・食物繊維・肥満対策が重要
- 大量出血・激痛・高熱などは、緊急受診が必要なサイン
大腸憩室炎は珍しい病気ではありませんが、進行すると短時間で重症化することがあります。
「いつもと違う痛み」「前と似た痛み」「長く続く微熱」など、少しでも不安があれば早めの受診が安全です。
適切な診断と治療によって、多くは良好に回復します。

監修:東京都豊島区おなかとおしりのクリニック 東京大塚
院長 端山 軍(MD, PhD Tamuro Hayama)
資格:日本消化器病学会認定 消化器病専門医・指導医
日本消化器内視鏡学会認定 消化器内視鏡専門医・指導医
日本大腸肛門病学会認定 大腸肛門病専門医・指導医・評議員
日本外科学会認定 外科専門医・指導医
日本消化器外科学会認定 消化器外科専門医・指導医
日本がん治療認定医機構認定 がん治療認定医
日本消化器外科学会認定 消化器がん外科治療認定医
帝京大学医学部外科学講座非常勤講師
元帝京大学医学部外科学講座准教授
医学博士 など
院長プロフィール